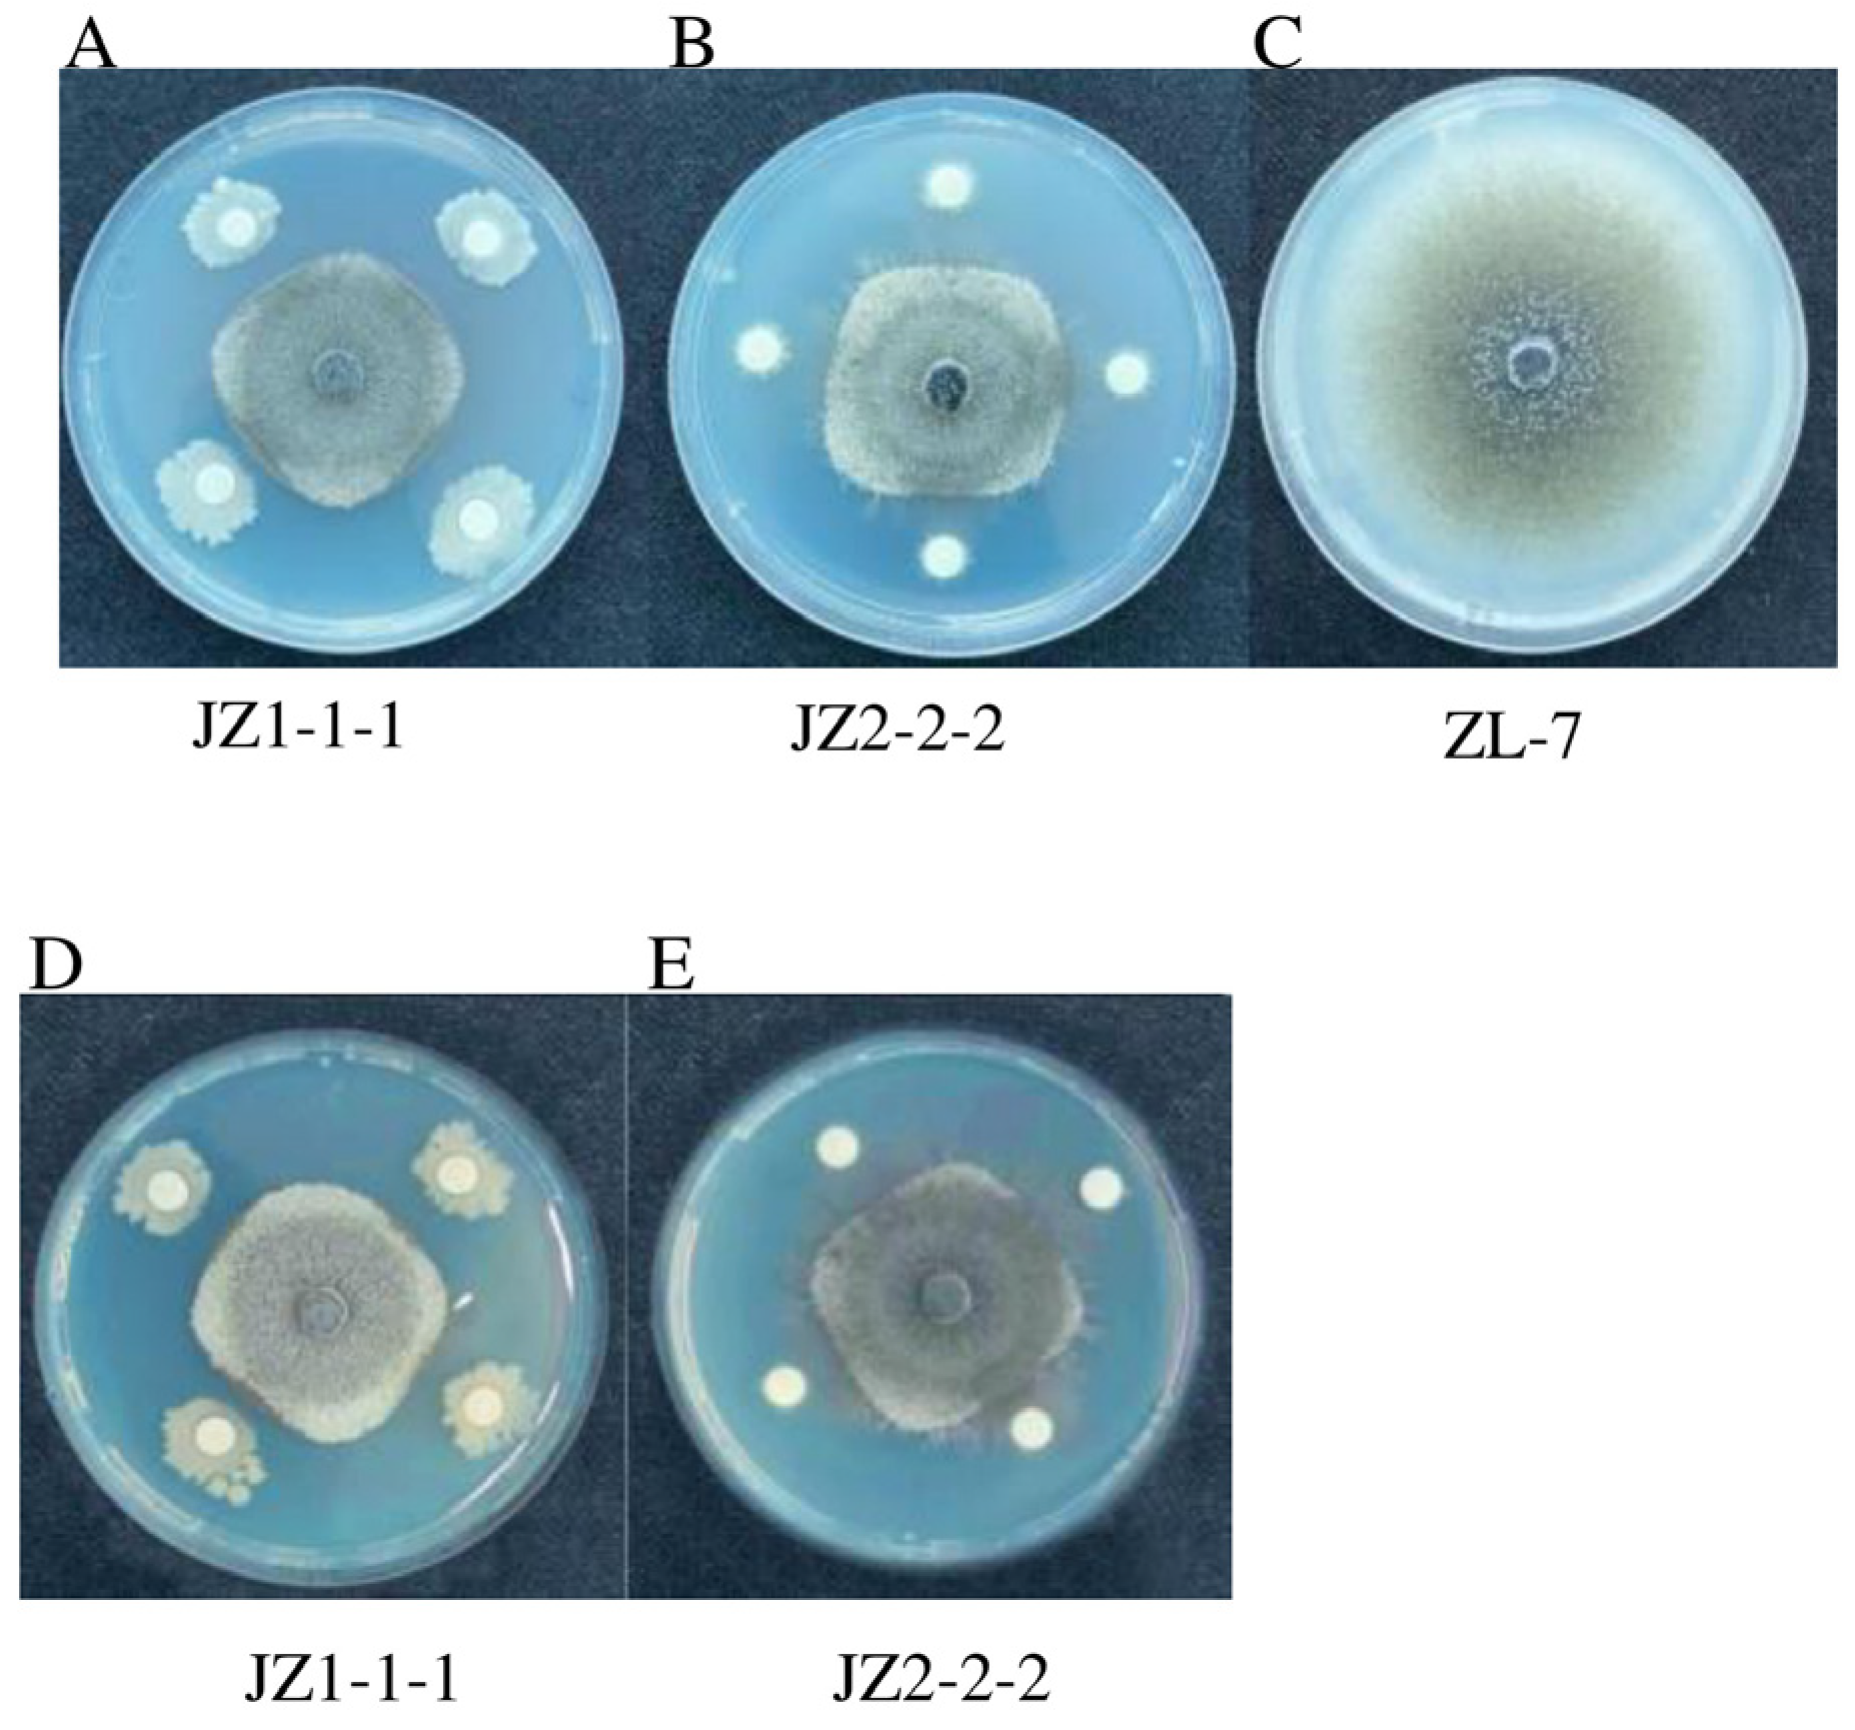
Jof 11 00121 g002
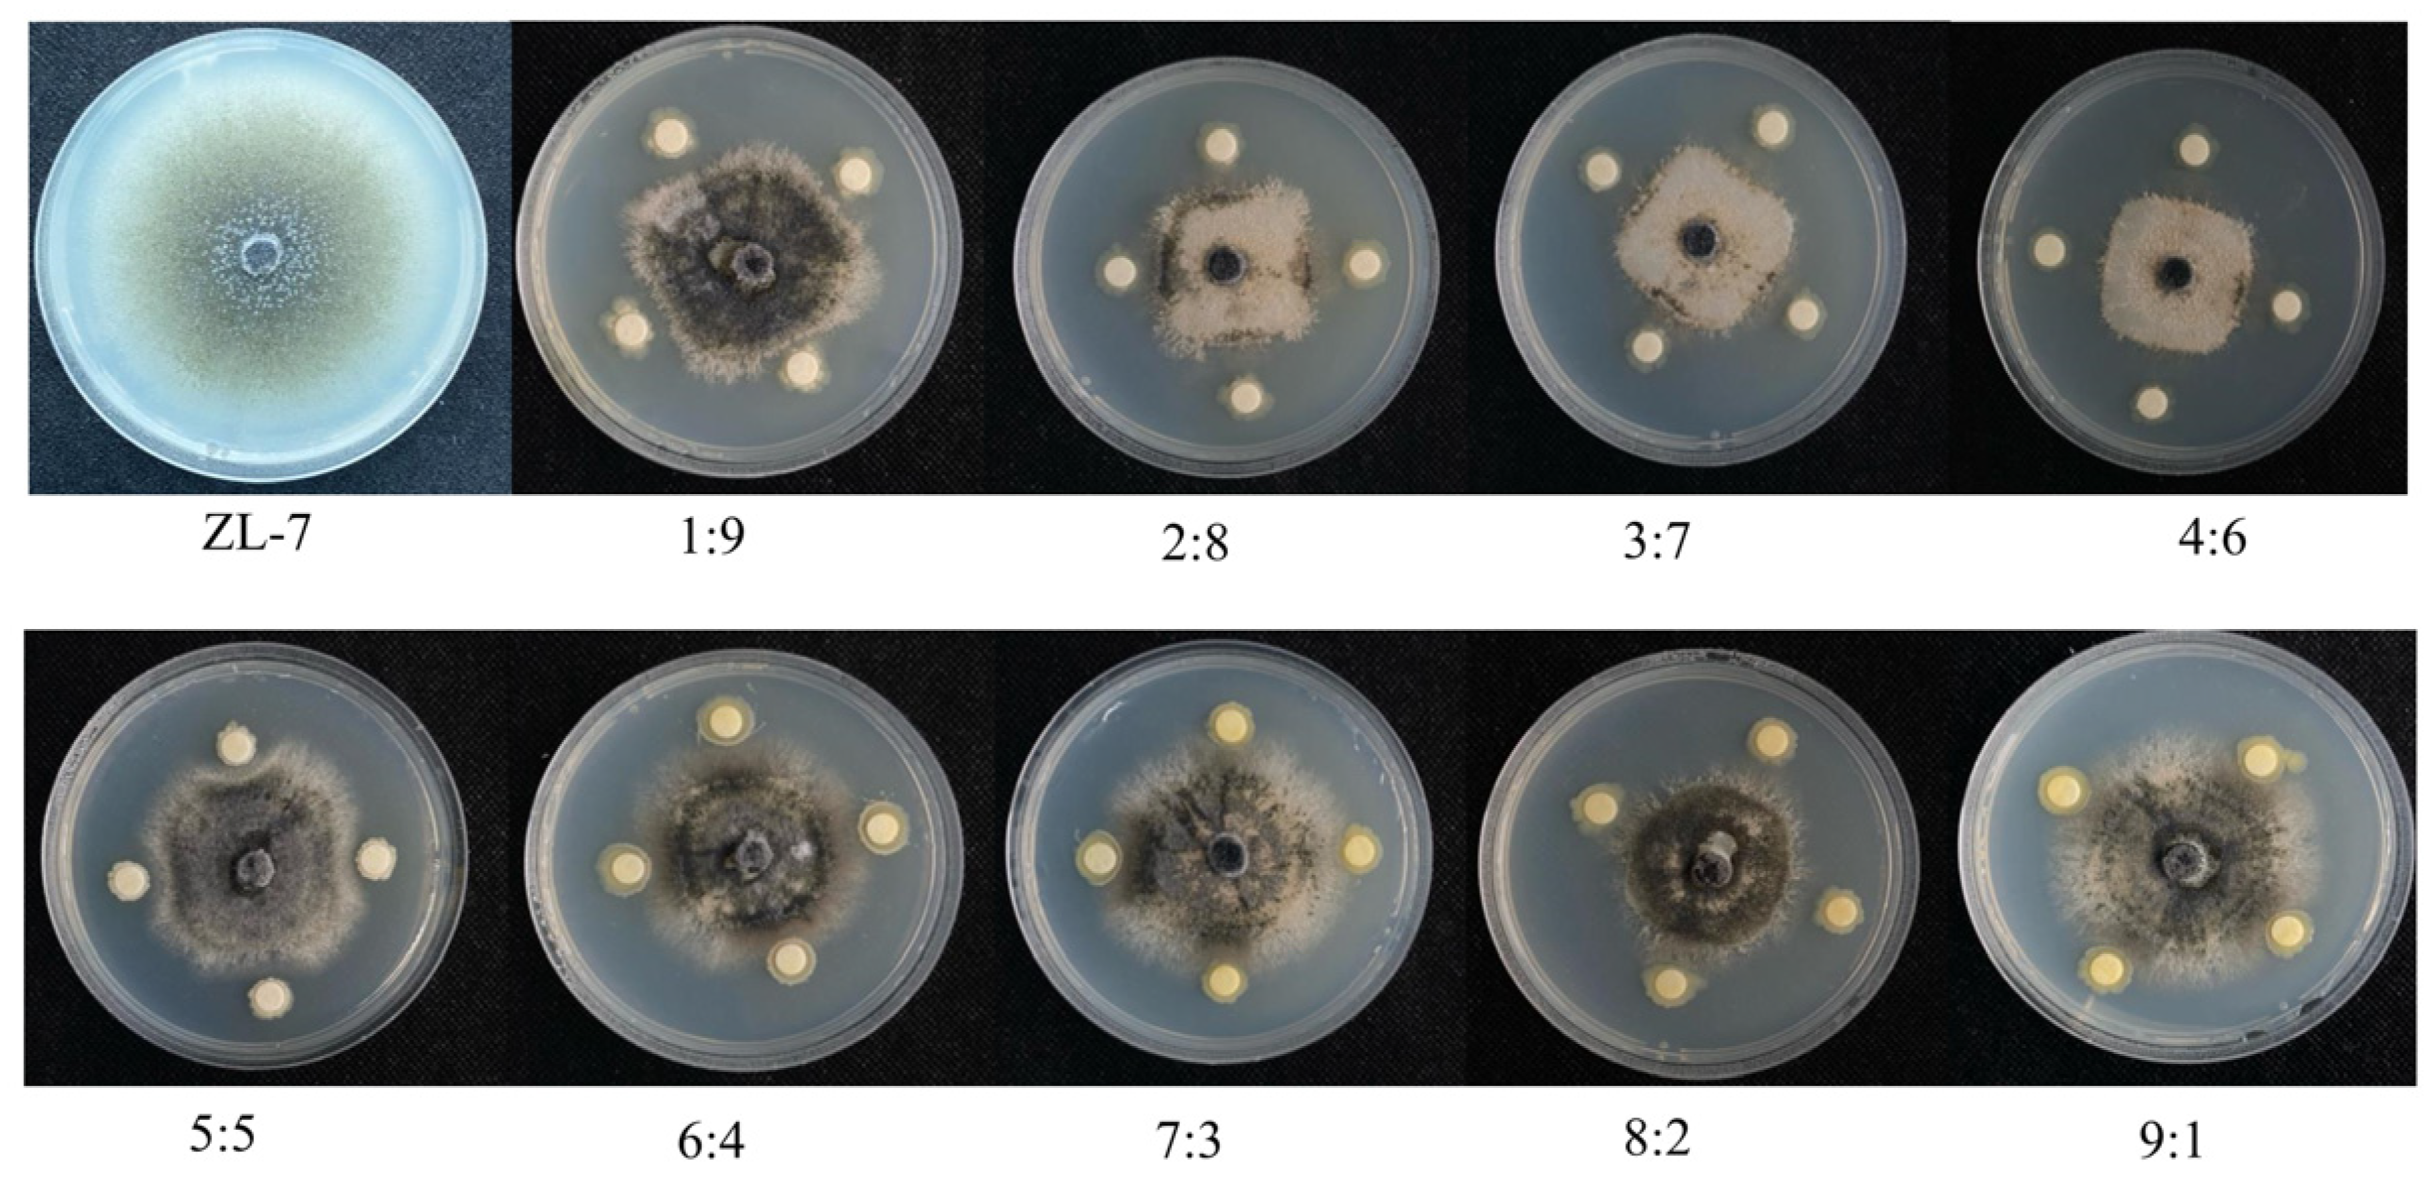
Jof 11 00121 g003

Pantoea–Bacillus as a Composite Microbial Community: Inhibition and Potential Mechanism Against Potato Anthracnose Disease
Abstract
1. Introduction
2. Materials and Methods
2.1. Isolation and Cultivation of Microorganisms
2.2. Identification of Microorganisms
2.3. Construction of the Composite Microbial Community
2.4. Determination of Antimicrobial Activity of Composite Microbial Communities
2.5. Determination of Biofilm Formation Ability of Mixed Microbial Communities
2.6. Control Effect of Composite Microbial Communities on Potato Anthracnose and Their Impact on Defense Enzyme Activity
2.7. Specific Design of Primers and Probes
2.8. Real-Time Quantitative PCR Analysis of the Colonization Ability of Complex Microbial Communities on Potato Tubers
2.9. Statistics and Analysis
3. Results
3.1. Identification of Biocontrol Bacteria
3.2. Antimicrobial Activity of the Composite Microbial Community Against Potato Anthracnose
3.3. Biofilm Formation Ability of the Composite Microbial Community
3.4. Determination of the Efficacy of Mixed Microbial Communities Against Potato Tuber Anthracnose
3.5. The Effect of the Composite Microbial Community on Defense Enzyme Activity Against Potato Anthracnose Disease
3.6. Specificity Verification of Primers and Probes
3.7. Fluorescent Quantitative PCR Analysis of the Colonization Ability of Composite Microbial Communities on Potato Tubers
4. Discussion
5. Conclusions
Author Contributions
Funding
Institutional Review Board Statement
Informed Consent Statement
Data Availability Statement
Conflicts of Interest
References
- Salehi, F.; Ghazvineh, S.; Amiri, M. Effect of basil seed gum coating and ultrasound pretreatment on frying time, oil uptake, hardness, color indexes, and sensory properties of potato slices. Ultrason. Sonochem. 2024, 110, 107035. [Google Scholar] [CrossRef] [PubMed]
- Resjö, S.; Wilford, J.; Large, A. Comparative proteomic analyses of potato leaves from field-grown plants grown under extremely long days. Plant Physiol. Biochem. 2024, 215, 109032. [Google Scholar] [CrossRef]
- Wang, Y.; Xu, Y.; Wang, X.; Wang, H.; Liu, S.; Chen, S.; Li, M. Optimizing the effects of potato size and shape on near-infrared prediction models of potato quality using a linear-nonlinear algorithm. J. Food Compos. Anal. 2024, 135, 106679. [Google Scholar] [CrossRef]
- Ferreira, C.L.P.; da Costa, D.S.; de Faria, R.A.P.G.; Bragotto, A.P.A. Acrylamide in alternative snacks to potato: A review. Food Res. Int. 2024, 194, 114931. [Google Scholar] [CrossRef] [PubMed]
- Wang, Z.J.; Liu, H.; Zeng, F.K.; Yang, Y.C.; Xu, D.; Zhao, Y.C.; Liu, X.F.; Kaur, L.; Liu, G.; Singh, J. Potato Processing Industry in China: Current Scenario, Future Trends and Global Impact. Potato Res. 2023, 66, 543–562. [Google Scholar] [CrossRef]
- Kumbar, B.; Mahmood, R.; Nagesha, S.N. Field application of Bacillus subtilis isolates for controlling late blight disease of potato caused by Phytophthora infestans. Biocatal. Agric. Biotechnol. 2019, 22, 101366. [Google Scholar] [CrossRef]
- Devi, A.R.; Sharma, G.D.; Majumdar, P.B. A multispecies consortium of bacteria having plant growth promotion and antifungal activities, for the management of Fusarium wilt complex disease in potato (Solanum tuberosum L.). Biocatal. Agric. Biotechnol. 2018, 16, 614–624. [Google Scholar] [CrossRef]
- Liu, F.; Hyde, K.D.; Cai, L. Neotypification of Colletotrichum coccodes, the causal agent of potato black dot disease and tomato anthracnose. Mycology 2011, 2, 248–258. [Google Scholar] [CrossRef]
- Kuznetsova, M.A.; Statsyuk, N.V.; Demidova, V.N.; Semeniuk, I.N.; Smetanina, T.I.; Ukolova, A.Y.; Vyatchinov, A.A. A complex approach to control black dot disease in potato. Agronomy 2024, 14, 1373. [Google Scholar] [CrossRef]
- Josep, M.C.; Sylvain, S.; Nicole, L.; Eric, D.; Brice, D.; Andreas, K.; Patrice, W.; Jean, L.W.; Katia, G.; Stéphanie, S. Influence of abiotic factors, inoculum source, and cultivar susceptibility on the potato tuber blemish diseases black dot (Colletotrichum coccodes) and silver scurf (Helminthosporium solani). Plant Pathol. 2021, 70, 885–897. [Google Scholar]
- Hassoon, I.M.; Qassir, S.A.; Riyadh, M. Pdcnn: A framework for potato diseases classification based on feed foreword neural network. Baghdad Sci. J. 2021, 18, 1012–1019. [Google Scholar] [CrossRef]
- Wei, Z.; Chen, A.; Luo, D. Isolation and identification of the pathogen of potato anthracnose in gansu province. Plant Prot. 2012, 38, 113–115. [Google Scholar]
- Tian, Z.M.; Wu, Y.H.; Guo, H.J. First report of potato black dot caused by Colletotrichum coccodes in Hebei Province of China. Plant Dis. 2019, 103, 2669. [Google Scholar] [CrossRef]
- Caulier, S.; Gillis, A.; Colau, G.; Licciardi, F.; Liépin, M.; Desoignies, N.; Modrie, P.; Legrève, A.; Mahillon, J.; Bragard, C. Versatile Antagonistic Activities of Soil-Borne Bacillus spp. and Pseudomonas spp. against Phytophthora infestans and Other Potato Pathogens. Front. Microbiol. 2018, 9, 143. [Google Scholar] [CrossRef]
- Maldani, M.; Aliyat, F.Z.; Morabito, M.; Giarratana, F.; Nassiri, L.; Ibijbijen, J. The effects of herbicide application on two soil phosphate solubilizing bacteria: Pantoea agglomerans and Serratia rubidaea. Ecotoxicology 2023, 32, 720–735. [Google Scholar] [CrossRef]
- Duchateau, S.; Crouzet, J.; Dorey, S.; Aziz, A. The plant-associated Pantoea spp. as biocontrol agents: Mechanisms and diversity of bacteria-produced metabolites as a prospective tool for plant protection. Biol. Control 2024, 188, 105441. [Google Scholar] [CrossRef]
- González, M.J.; Ramos, C. Biological control of bacterial wilt using Pseudomonas spp. Plant Pathol. J. 2010, 26, 392–399. [Google Scholar]
- Lin, D.L.; Huang, Y.S.; Ma, Y.C. Seed-borne bacterial synthetic community resists seed pathogenic fungi and promotes plant growth. J. Appl. Microbiol. 2024, 4, 135. [Google Scholar]
- Li, X.; Liu, Q.; Gao, Y. Effects of a co-bacterial agent on the growth, disease control, and quality of ginseng based on rhizosphere microbial diversity. BMC Plant Biol. 2024, 24, 647. [Google Scholar] [CrossRef]
- Krüger, A.P.; Garcez, A.M.; Scheunemann, T. Trichopria anastrephae as a biological control agent of Drosophila suzukii in strawberries. Neotrop. Entomol. 2024, 53, 216–224. [Google Scholar] [CrossRef]
- Panchami, P.S.; Geetha Thanuja, K.; Karthikeyan, S. Isolation and Characterization of Indigenous Plant Growth-Promoting Rhizobacteria (PGPR) from Cardamom Rhizosphere. Curr. Microbiol. 2020, 77, 2963–2981. [Google Scholar] [CrossRef] [PubMed]
- Wen, Y.; Zhao, G.; Zhou, C.; Cao, A. Research Progress on microbial agents in the field of ecological engineering. Acta Ecol. Sin. 2011, 31, 6287–6294. [Google Scholar]
- Kuang, A.; Fu, X.; Liu, Z.; Chen, Q.; Jin, R.; Mao, H. Biocontrol effect of the complex inoculants of trichoderma and Bacillus amyloliquefaciens on chrysanthemum white rust. Biocatal. Agric. Biotechnol. 2024, 56, 103010. [Google Scholar]
- Nugrah, B.D.; Pambudi, A.; Effendi, Y. Expression of nutrient uptake-related genes in response to beneficial bacterial consortium application on Musa acuminata. IOP Conf. Ser. Earth Environ. Sci. 2023, 1271, 012011. [Google Scholar] [CrossRef]
- Xu, J.; Lu, Y.; Shan, G. Inoculation with compost-born thermophilic complex microbia-l consortium induced organic matters degradation while reduced nitrogen loss during co-composting of dairy manure and sugarcane leaves. Waste Biomass Valorization 2019, 10, 2467–2477. [Google Scholar] [CrossRef]
- Glick, B.R. Plant growth-promoting bacteria: Mechanisms and applications. Scientifica 2012, 96, 3401. [Google Scholar] [CrossRef]
- Chen, Y.; Zhang, J. Isolation and identification of Bacillus subtilis from soil and its potential for biocontrol of plant diseases. Plant Pathol. J. 2018, 34, 267–275. [Google Scholar]
- Wang, L.; Zhang, Y.; Liu, C. Molecular identification and phylogenetic analysis of Bacillus species based on 16S rDNA and gyrA sequences. Int. J. Syst. Evol. Microbiol. 2019, 69, 2267–2275. [Google Scholar]
- Kim, Y.J.; Cho, J.H. Molecular identification of Pantoea species using 16S rRNA and gyrB gene sequencing. J. Microbiol. Biotechnol. 2017, 27, 678–685. [Google Scholar]
- Kearney, B.; Kearney, S. PCR amplification of bacterial genes for identification and characterization. Methods Microbiol. 2020, 47, 185–205. [Google Scholar]
- Wu, H.; Chen, H. A comprehensive study on the phylogenetic relationships of Bacillus and related genera based on multi-gene sequence analysis. BMC Microbiol. 2018, 18, 205. [Google Scholar]
- Kumar, S.; Stecher, G.; Li, M.; Knyaz, C.; Tamura, K. MEGA X: Molecular Evolutionary Genetics Analysis across Computing Platforms. Mol. Biol. Evol. 2018, 35, 1547–1549. [Google Scholar] [CrossRef] [PubMed]
- Yuan, Y.; Chen, Y. Influence of temperature and pH on the growth and metabolite production of Escherichia coli. J. Ind. Microbiol. Biotechnol. 2023, 50, 1–10. [Google Scholar]
- Zhao, L.; Xu, J. Recent advances in the fermentation technology for microbial production of biochemicals. Biotechnol. Adv. 2023, 61, 107989. [Google Scholar]
- Khan, M.I.; Sultana, S. Antimicrobial activity of various plant extracts: A review. Int. J. Pharm. Sci. Res. 2016, 7, 1969–1975. [Google Scholar]
- Banerjee, S.; Das, S.; Rai, C.; Bhattacharyya, S.; Roy, A. Evaluation of detection methods of biofilm formation by Bacillus cereus and Staphylococcus aureus isolates from foods. Res. J. Life Sci. Chem. Sci. 2018, 4, 147–155. [Google Scholar]
- Arshad, U.; Altaf, M.T.; Liaqat, W.; Ali, M.; Shah, M.N.; Jabran, M.; Ali, M.A. Biochar: Black gold for sustainable agriculture and fortification against plant pathogens—A review. J. Crop Health 2024, 76, 385–396. [Google Scholar] [CrossRef]
- Ben Naim, Y.; Cohen, Y. Replacing mancozeb with alternative fungicides for the control of late blight in potato. J. Fungi 2023, 9, 1046. [Google Scholar] [CrossRef]
- Shi, Z.; Wang, F.; Lu, Y.; Deng, J. Combination of chitosan and salicylic acid to control postharvest green mold caused by Penicillium digitatum in grapefruit fruit. Sci. Hortic. 2018, 233, 54–60. [Google Scholar] [CrossRef]
- Zhang, J.; Xie, J.; Zhou, Y.; Deng, L.; Yao, S.; Zeng, K. Inhibitory effect of Pichia membranaefaciens and Kloeckera apiculata against Monilinia fructicola and their biocontrol ability of brown rot in postharvest plum. Biol. Control 2017, 114, 51–58. [Google Scholar] [CrossRef]
- Liu, W.; Zhang, Y. Design of specific primers for the identification of pathogenic bacteria based on 16S rDNA sequences. Mol. Biol. Rep. 2008, 35, 1–6. [Google Scholar]
- Vandesompele, J.; De Preter, K.; Pattyn, F.; Poppe, B.; Van Roy, N.; De Paepe, A.; Speleman, F. Accurate normalization of real-time quantitative RT-PCR data by geometric averaging of multiple internal control genes. Genome Biol. 2002, 3, research0034.1. [Google Scholar] [CrossRef] [PubMed]
- Promchai, R.; Promdonkoy, B.; Tanapongpipat, S.; Visessanguan, W.; Eurwilaichitr, L.; Luxananil, P. A novel salt-inducible vector for efficient expression and secretion of heterologous proteins in Bacillus subtilis. J. Biotechnol. 2016, 222, 86–93. [Google Scholar] [CrossRef] [PubMed]
- Kearse, M.; Moir, R.; Wilson, A.; Stones-Havas, S.; Cheung, M.; Sturrock, S.; Buxton, S.; Cooper, A.; Markowitz, S.; Duran, C.; et al. Geneious Basic: An integrated and extendable desktop software platform for the organization and analysis of sequence data. Bioinformatics 2012, 28, 1647–1649. [Google Scholar] [CrossRef]
- Mishra, A.; Gupta, N. Role of Bacillus species in promoting plant growth and controlling plant diseases. J. Plant Pathol. 2016, 98, 1–10. [Google Scholar]
- Rokaya, S.D. Antimicrobial activity of bacterial metabolites: A review. J. Appl. Microbiol. 2020, 128, 1283–1295. [Google Scholar]
- Xin, W.G.; Li, X.D.; Zhou, H.Y.; Li, X.; Liu, W.X.; Lin, L.B.; Wang, F. Isolation, antibacterial characterization, and alternating tangential flow-based preparation of viable cells of Lacticaseibacillus paracasei XLK 401: Potential application in milk preservation. J. Dairy Sci. 2024, 107, 1355–1369. [Google Scholar] [CrossRef]
- Freimoser, F.M.; Rueda-Mejia, M.P.; Tilocca, B.; Migheli, Q. Biocontrol yeasts: Mechanisms and applications. World J. Microbiol. Biotechnol. 2019, 35, 154. [Google Scholar] [CrossRef]
- Vero, S.; Garmendia, G.; González, M.B.; Bentancur, O.; Wisniewski, M. Evaluation of yeasts obtained from Antarctic soil samples as biocontrol agents for the management of postharvest diseases of apple (Malus × domestica). FEMS Yeast Res. 2013, 13, 189–199. [Google Scholar] [CrossRef]
- Yi, J.; Zhang, D.; Cheng, Y.; Tan, J.; Luo, Y. The impact of Paenibacillus polymyxa HY96-2 luxS on biofilm formation and control of tomato bacterial wilt. Appl. Microbiol. Biotechnol. 2019, 103, 9643–9657. [Google Scholar] [CrossRef]
- Flemming, H.-W.; Wingender, J. The biofilm matrix. Nat. Rev. Microbiol. 2016, 14, 563–578. [Google Scholar] [CrossRef] [PubMed]
- Huang, Y.; Chen, Y. The effects of metabolic by-products on biofilm formation by Pseudomonas aeruginosa. J. Microbiol. 2015, 53, 241–247. [Google Scholar]
- Montesinos, E. Functional Peptides for Plant Disease Control. Annu. Rev. Phytopathol. 2023, 61, 301–324. [Google Scholar] [CrossRef] [PubMed]
- Foolad, M.R. Genetic Diversity and Resistance to Disease in Potato. Plant Dis. 2007, 91, 235–243. [Google Scholar]
- Kharshandi, F.; Kayang, H. Antagonistic potential of rhizobacterial isolates against fungal pathogens causing rhizome rot in turmeric. Arch. Microbiol. 2023, 205, 221. [Google Scholar] [CrossRef]
- Naselli, M.; Urbaneja, A.; Siscaro, G.; Jaques, J.A.; Zappalà, L.; Flors, V.; Pérez-Hedo, M. Stage-related defense response induction in tomato plants by Nesidiocoris tenuis. Int. J. Mol. Sci. 2016, 17, 1210. [Google Scholar] [CrossRef]
- Jinal, N.H.; Amaresan, N. Evaluation of biocontrol Bacillus species on plant growth promotion and systemic-induced resistant potential against bacterial and fungal wilt-causing pathogens. Arch. Microbiol. 2020, 202, 1785–1794. [Google Scholar] [CrossRef]
- Kloepper, J.W.; Ryu, C.M.; Zhang, S. Induced systemic resistance and promotion of plant growth by Bacillus species. Phytopathology 2004, 94, 1259–1266. [Google Scholar] [CrossRef]
- Poveda, J.; Fuente, J.A.; Romero, F. Microbial inoculants for sustainable agriculture: A review. Agronomy 2020, 10, 537. [Google Scholar]

| Gene | Primer | Primer Sequences |
|---|---|---|
| 16sDNA | F | AGAGTTTGATCCTGGCTCAG |
| R | GGTTACCTTGTTACGACTT | |
| gyrA | gyrA-F | CAGTCAGGAAATGCGTACGTCCTT |
| gyrA-R | CAAGGTAATGCTCCAGGCATTGCT | |
| atpD | atpD-F | ACAAGTTTGTCTTCCTCGCC |
| atpD-R | TGAGGTCGCTCTTCTTTAGG | |
| rpoB | rpoB-F | GGAAACCGCCGTTTTACGTTC |
| rpoB-R | CCATGAGGCACACGAAGAGA | |
| gyrB | gyrB-F | ATTGGTGACACCGATCAAACA |
| gyrB-R | TCATACGTATGGATGTTATTC | |
| frr | frr-F | AAACCACCATCAGCAAAG |
| frr-R | TTGGGTTCAGACCGAGAT | |
| rpoD | rpoD-F | TAGCCGAATACCCTGAAGC |
| rpoD-R | AAATCGCCCAGATGTGAA | |
| ITS | F | GGTTTTGATCCTTGTCTCCAG |
| R | GGTTACCTGTTACGACTT |
| Fermentation Broth | Bacterial Suspension | |||
|---|---|---|---|---|
| Strain | Colony Diameter (cm) | Inhibitory Rate (%) | Colony Diameter (cm) | Inhibitory Rate (%) |
| ZL-7 | 7.01 ± 0.12 a | - | - | - |
| JZ1-1-1 | 3.43 ± 0.08 b | 51.46 | 3.17 ± 0.05 c | 55.21 |
| JZ2-2-2 | 3.61 ± 0.07 b | 48.9 | 3.29 ± 0.06 c | 53.48 |
| Bacterial Suspension | ||
|---|---|---|
| Strain | Colony Diameter (cm) | Inhibitory Rate (%) |
| ZL-7 | 7.01 ± 0.12 a | - |
| JZ1-1-1 and JZ2-2-2 (1:9) | 4.05 ± 0.09 c | 42.65 |
| JZ1-1-1 and JZ2-2-2 (2:8) | 3.56 ± 0.05 d | 49.71 |
| JZ1-1-1 and JZ2-2-2 (3:7) | 3.21 ± 0.04 e | 54.75 |
| JZ1-1-1 and JZ2-2-2 (4:6) | 2.25 ± 0.03 f | 68.58 |
| JZ1-1-1 and JZ2-2-2 (5:5) | 5.52 ± 0.10 b | 21.46 |
| JZ1-1-1 and JZ2-2-2 (6:4) | - | - |
| JZ1-1-1 and JZ2-2-2 (7:3) | - | - |
| JZ1-1-1 and JZ2-2-2 (8:2) | 3.89 ± 0.07 c | 44.95 |
| JZ1-1-1 and JZ2-2-2 (9:1) | - | - |
| Treatment Group | Lesions Diameter (cm) | Control Effect (%) | Weight Loss (%) |
|---|---|---|---|
| CK | 0.98 ± 0.02 e | - | 5.85 |
| T | 3.98 ± 0.15 a | - | 22.58 |
| X | 1.64 ± 0.05 c | 71.34 | 8.24 |
| Y | 1.31 ± 0.06 d | 81.40 | 7.01 |
| Z | 2.21 ± 0.03 b | 44.47 | 15.45 |
| M | 1.12 ± 0.04 e | 87.19 | 6.75 |
| No. | Strain | Ct | GenBank Acc. No. |
|---|---|---|---|
| 1 | Pantoea agglomerans JZ1-1-1 | 29.85 | PQ849068 |
| 2 | Potato tuber | nd | - |
| 3 | JZ1-1-1 and potato tuber + potato tuber | 26.60 | - |
| 4 | Bacillus subtilis JZ2-2-2 | 28.74 | PQ849069 |
| 5 | JZ2-2-2 and potato tuber + potato tuber | 25.72 | - |
| 6 | Bacillus amyloliquefaciens QS10-6 | nd | PQ856826 |
| 7 | Bacillus atrophaeus QS2-5 | nd | PQ856824 |
| 8 | Bacillus velezensis QS2-13 | nd | PQ856825 |
| 9 | Bacillus safensis BM-7 | nd | P0835495 |
| 10 | Bacillus atrophaeus QB-2-7 | nd | PQ835496 |
Disclaimer/Publisher’s Note: The statements, opinions and data contained in all publications are solely those of the individual author(s) and contributor(s) and not of MDPI and/or the editor(s). MDPI and/or the editor(s) disclaim responsibility for any injury to people or property resulting from any ideas, methods, instructions or products referred to in the content. |
© 2025 by the authors. Licensee MDPI, Basel, Switzerland. This article is an open access article distributed under the terms and conditions of the Creative Commons Attribution (CC BY) license (https://creativecommons.org/licenses/by/4.0/).
Share and Cite
Zhang, H.; Shi, H.; Luo, M.; Li, Y.; Li, W.; Wang, J.; Shen, S. Pantoea–Bacillus as a Composite Microbial Community: Inhibition and Potential Mechanism Against Potato Anthracnose Disease. J. Fungi 2025, 11, 121. https://doi.org/10.3390/jof11020121
Zhang H, Shi H, Luo M, Li Y, Li W, Wang J, Shen S. Pantoea–Bacillus as a Composite Microbial Community: Inhibition and Potential Mechanism Against Potato Anthracnose Disease. Journal of Fungi. 2025; 11(2):121. https://doi.org/10.3390/jof11020121
Chicago/Turabian StyleZhang, Haojie, Huiqin Shi, Mingkai Luo, Yanan Li, Wei Li, Jian Wang, and Shuo Shen. 2025. "Pantoea–Bacillus as a Composite Microbial Community: Inhibition and Potential Mechanism Against Potato Anthracnose Disease" Journal of Fungi 11, no. 2: 121. https://doi.org/10.3390/jof11020121
APA StyleZhang, H., Shi, H., Luo, M., Li, Y., Li, W., Wang, J., & Shen, S. (2025). Pantoea–Bacillus as a Composite Microbial Community: Inhibition and Potential Mechanism Against Potato Anthracnose Disease. Journal of Fungi, 11(2), 121. https://doi.org/10.3390/jof11020121





